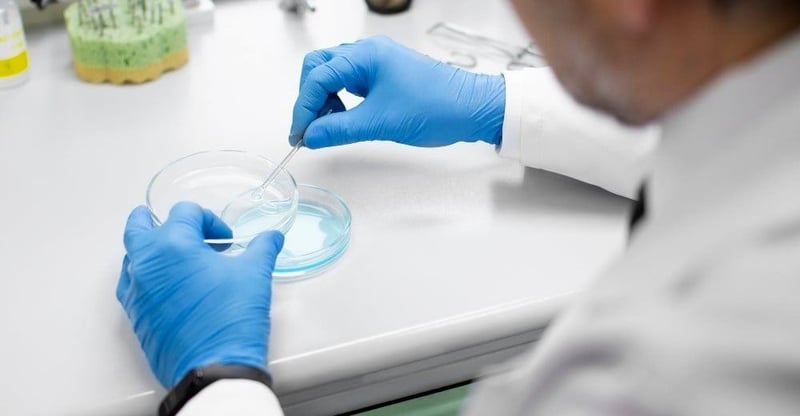
New Evidence Suggests Behavioural Change Not Awareness Is Key To Tackling Antibiotic Resistance

New Evidence Suggests Behavioural Change Not Awareness Is Key To Tackling Antibiotic Resistance
Written by: BizCommunity Editor Save to Instapaper
Antimicrobial resistance happens when disease-causing microbes such as bacteria, viruses, fungi and parasites develop resistance to antimicrobials (the medicinal substances used to control them). This leads to treatable infections becoming life-threatening.
The World Health Organization, other organisations, networks and alliances run extensive campaigns designed to educate the public about antimicrobial resistance. But a question remains after more than a decade of global campaigns: has all this awareness-raising actually helped combat antimicrobial resistance?
I am a science communication researcher and a member of a global convening on “Just Transitions for Antimicrobial Resistance” funded by the British Academy. We conducted research into the challenges of communicating about antimicrobial resistance and how effective these efforts have been.
We did a scoping review of 88 published studies between 2015 and 2024. Our review shows that most efforts to communicate about antimicrobial resistance still rely on one-way awareness campaigns. But simply giving people more information does little to change behaviour. It is even more critical when the messages ignore the social, cultural and economic realities that shape everyday decisions.
To make real progress, antimicrobial communication needs to shift towards approaches that are grounded in people’s lived experiences. It must be participatory, locally relevant and justice-oriented. It must also be informed by social and behavioural science. Better evaluation of existing efforts to communicate about this complex health threat is important too.
Barriers to effective campaign
For years, many antimicrobial resistance campaigns have relied on a simple assumption. That is, if people understand what it is, they will use antimicrobials more judiciously. Antimicrobial resistance increases when we take medicines in the wrong doses, or for the wrong reasons. For example, when we take antibiotics for a viral infection or share leftover antibiotics. Also, when we stop taking prescribed medication too soon.
But behavioural science has repeatedly shown that decisions about science and health are shaped far more by other issues than by factual knowledge alone. Emotion, identity, social norms and lived experience influence what people do.
A message like “use antibiotics responsibly” cannot succeed if it does not match people’s real-life experiences. When people live far from their nearest clinic or when healthcare services are unaffordable, they might save leftover medication for future use or share it with others. Clinicians, working under pressure in crowded facilities, may also feel compelled to prescribe antibiotics to meet patients’ expectations after a long wait. On dairy, chicken and pig farms, farmers might regularly add antibiotics to animal feed to prevent costly disease outbreaks.
A second major barrier is the language used to communicate antimicrobial resistance. Technical terms like “antimicrobial resistance”, “stewardship” or “drug-resistant infections” are difficult to pronounce, remember or relate to. They are also often hard to translate into local languages. The language used often fails to resonate with public audiences. Messages about antimicrobial resistance may feel distant, abstract and removed from everyday life. They may also be so threatening that people tend to disengage. Some experts are even calling for a renaming of antimicrobial resistance, based on co-designing new terminologies with local communities.
Another critical gap is the lack of messages that offer clear, practical and achievable steps people can take. Many campaigns highlight the scale of the crisis but leave people unsure of what to do. This contributes to anxiety or fatalism. People need concrete and actionable calls to action that make sense in their daily lives. There is also an urgent need to identify and agree on what behavioural changes are desirable, relevant and feasible in different contexts.
Moving forward
Tailoring communication to specific audiences is also essential. One-size-fits-all messaging does not work across diverse social, cultural and linguistic contexts. Parents, farmers, community health workers, pharmacists and clinicians all interact with medicines differently. They equally face different constraints. Therefore, audience segmentation is crucial, and messages must be tailored to local communities.
The evidence is also clear that antimicrobial communication must move from top-down instruction to genuine public engagement. Participatory approaches and engagement activities have proven effective in building trust, addressing misinformation, and strengthening local ownership of antimicrobial challenges. They include storytelling, online games and community dialogues.
Communities can and should be co-creators of culturally relevant knowledge and solutions.
Importantly, antimicrobial resistance is deeply intertwined with inequality. Low- and middle-income countries face a disproportionate burden of resistant infections, for many reasons. Overcrowding, limited sanitation, constrained healthcare systems and unequal access to diagnosis or treatment are some of them. Communication strategies that ignore these systemic inequities risk reinforcing stigma or placing blame on individuals. People should be treated not only as health consumers but as citizens navigating complex structural challenges.
Public health experts often describe antimicrobial resistance as a “super‑wicked” problem.
It is complex, slow-moving, and embedded in social and economic realities, requiring urgent solutions. It is also full of uncertainty and complexity.
Addressing it requires communication approaches that are as nuanced, sophisticated and intersectional as the challenge itself.
It is time to rethink what antimicrobial communication should and could achieve. Raising awareness is only a starting point.
Communication must be informed by behaviour, locally grounded and emotionally compelling. It must be created with communities.
It must use clear language, avoid jargon, and provide specific actions that people can realistically adopt.
It must highlight both the urgency of antimicrobial resistance and the agency that individuals and communities possess. In this way, communication itself has the potential to become an integral part of the solution via collective problem-solving.
This article is republished from The Conversation under a Creative Commons license. Read the original article.
Get new press articles by email
We submit and automate press releases distribution for a range of clients. Our platform brings in automation to 5 social media platforms with engaging hashtags. Our new platform The Pulse, allows premium PR Agencies to have access to our newsletter subscribers.
Latest from
- Industry Leaders Warn Of Continued Volatility In South Africa’s Beef Sector Through 2026
- Al Baraka Launches Shari’ah-Compliant Multi-Currency Visa Solution For Global Travellers
- Property Experts Share Practical Steps To Help Renters Move Toward Home Ownership
- Hilton Announces Three New DoubleTree Hotels As Part Of Its African Growth Strategy
- African Energy Chamber Highlights Role Of Natural Gas And LNG In Securing Africa’s Energy Future
- Inmed South Africa Transforms Lives Through Social Employment And Community Empowerment
- Experts Identify Top Five Global Markets For South African SMEs To Target In 2026
- DGB Receives International Ethical Award For Advancing Education Through Travelling Classrooms
- Offshore Energy Boom Spurs Investment In Advanced Logistics Hubs Across The Caribbean
- BYD’s Electric Vehicle Strategy Highlights The Steps Legacy Automakers Must Take To Catch Up
- Boikanyo Malepe Reflects On A Defining Year For Ethical And Community-Driven Journalism
- African Energy Chamber And ccCASH Launch Landmark Partnership To Support Clean Cooking Finance
- Affinity Health Warns Festive Season Strain Could Impact Employee Mental Health And Productivity
- Experts Warn Consumers Of Rising Hidden Dangers Linked To Shopping Through Social Media Platforms
- Study Highlights Growing Millennial Demand For Creative Tourism Experiences In South Africa
The Pulse Latest Articles
- Zuru Turns Fifa World Cup 2026™ Into The Next Global Collectibles Phenomenon (December 17, 2025)
- A Refreshing Spin On A Joburg Roadblock With Pura Soda And Saps (December 17, 2025)
- Education Is The Frontline Of Inequality, Business Must Show Up (December 11, 2025)
- When The Purple Profile Pictures Fade, The Real Work Begins (December 11, 2025)
- Dear Santa, Please Skip The Socks This Year (December 10, 2025)
